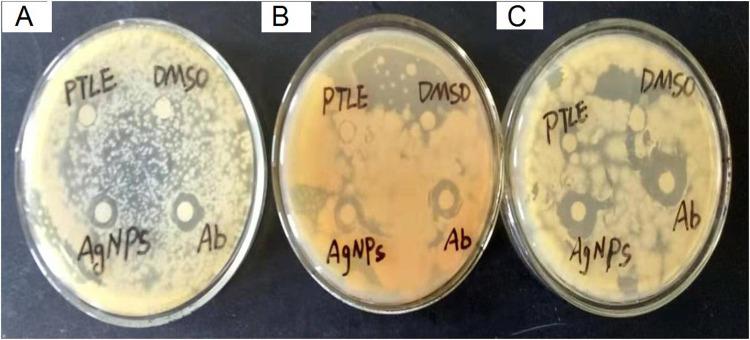
https://cdn.ncbi.nlm.nih.gov/pmc/blobs/fd43/7802595/86519deb1690/IJN-16-15-g0009.jpg

利用叶提取物合成银纳米粒子:抗菌、抗氧化和抗癌活性的表征和评价。
Phytosynthesis of Silver Nanoparticles Using Leaf Extract: Characterization and Evaluation of Antibacterial, Antioxidant, and Anticancer Activities.
机构信息
School of Chemical Engineering and Technology, North University of China, Taiyuan, Shanxi Province, People's Republic of China.
Pharmacology and Toxicology Division, Indian Institute of Chemical Engineering and Technology, Hyderabad, Telangana State, India.
出版信息
Int J Nanomedicine. 2021 Jan 6;16:15-29. doi: 10.2147/IJN.S265003. eCollection 2021.
PURPOSE
The present study investigates the phytosynthesis of silver nanoparticles (AgNPs) using leaf extract, which acts as a reducing agent for the conversion of silver ions (Ag+) into AgNPs. leaf synthesized AgNPs (PF@AgNPs) were evaluated for biomedical properties including antibacterial, antioxidant and anticancer activities.
MATERIALS AND METHODS
PF@AgNPs were synthesized using leaf extract and silver nitrate solution. The morphology and physical properties of PF@AgNPs were studied by spectroscopic techniques including, UV-Vis, FTIR, TEM, XRD, DLS, and TGA. Antibacterial activity of PF@AgNPs was evaluated by disk diffusion assay. Antioxidant activity of PF@AgNPs was checked by 2.2-diphenyl-1-picrylhydrazyl (DPPH), and 2.2'-azino-bis (3-ethylbenzothiazoline-6-sulfonic acid) (ABTS) free radical scavenging assays. Anticancer activity of PF@AgNPs was checked by 3-(4,5-dimethylthiazol-2-yl)-2,5-diphenyl tetrazolium bromide assay. Cytotoxic effects of PF@AgNPs on most susceptible cancer cell lines were observed by phase contrast microscopy.
RESULTS
PF@AgNPs showed surface plasmon resonance peak at 461 nm. XRD pattern showed that the PF@AgNPs were face-centered cubic crystals with a mean size of 25.71 nm. TEM analysis revealed the different shapes (spherical, rhombic, triangle, and rod) of PF@AgNPs. Zeta potential value (-25.83 mV) indicated that PF@AgNPs were long-term stable and not agglomerated. A low polydispersity index value (0.389) indicated the monodispersity of PF@AgNPs. TGA revealed the high thermal stability of PF@AgNPs. PF@AgNPs exhibited maximum inhibition against , followed by and . PF@AgNPs showed maximum inhibition of 68.02 and 62.93% against DPPH and ABTS-free radicals, respectively. PF@AgNPs showed significant anticancer activity against human colon cancer (COLO205) and prostate adenocarcinoma (LNCaP). PF@AgNPs exhibited apoptotic effects on LNCaP cells including cell shrinkage, membrane blebbing, chromatin condensation, fragmentation of nuclei, and formation of apoptotic bodies.
CONCLUSION
The present study reports the successful synthesis of PF@AgNPs using leaf extract. The synthesized PF@AgNPs are FCC crystals, monodispersed, long-term stable, and non-agglomerated. The observed antibacterial, antioxidant, and anticancer activities demonstrate the potential biomedical applications of PF@AgNPs.
目的
本研究使用叶片提取物合成银纳米粒子(AgNPs),叶片提取物作为将银离子(Ag+)转化为 AgNPs 的还原剂。评估了叶片合成的 AgNPs(PF@AgNPs)的生物医学特性,包括抗菌、抗氧化和抗癌活性。
材料和方法
使用叶片提取物和硝酸银溶液合成 PF@AgNPs。使用光谱技术,包括紫外-可见分光光度法、傅里叶变换红外光谱法、透射电子显微镜、X 射线衍射、动态光散射和热重分析,研究了 PF@AgNPs 的形态和物理性质。通过圆盘扩散法评估 PF@AgNPs 的抗菌活性。通过 2,2-二苯基-1-苦基肼(DPPH)和 2,2'-联氮-双(3-乙基苯并噻唑啉-6-磺酸)(ABTS)自由基清除测定法检查 PF@AgNPs 的抗氧化活性。通过 3-(4,5-二甲基噻唑-2-基)-2,5-二苯基四唑溴化物测定法检查 PF@AgNPs 的抗癌活性。通过相差显微镜观察 PF@AgNPs 对最敏感的癌细胞系的细胞毒性作用。
结果
PF@AgNPs 在 461nm 处显示出表面等离子体共振峰。X 射线衍射图谱表明,PF@AgNPs 为面心立方晶体,平均粒径为 25.71nm。TEM 分析显示了 PF@AgNPs 的不同形状(球形、菱形、三角形和棒形)。Zeta 电位值(-25.83mV)表明 PF@AgNPs 长期稳定且不聚集。低多分散指数值(0.389)表明 PF@AgNPs 的单分散性。TGA 揭示了 PF@AgNPs 的高热稳定性。PF@AgNPs 对 表现出最大的抑制作用,其次是 和 。PF@AgNPs 对 DPPH 和 ABTS 自由基的最大抑制率分别为 68.02%和 62.93%。PF@AgNPs 对人结肠癌细胞(COLO205)和前列腺腺癌(LNCaP)表现出显著的抗癌活性。PF@AgNPs 在 LNCaP 细胞上表现出凋亡作用,包括细胞收缩、膜泡形成、染色质浓缩、核碎裂和凋亡小体形成。
结论
本研究报告了使用叶片提取物成功合成 PF@AgNPs。合成的 PF@AgNPs 为 FCC 晶体,单分散,长期稳定,不聚集。观察到的抗菌、抗氧化和抗癌活性表明 PF@AgNPs 具有潜在的生物医学应用。